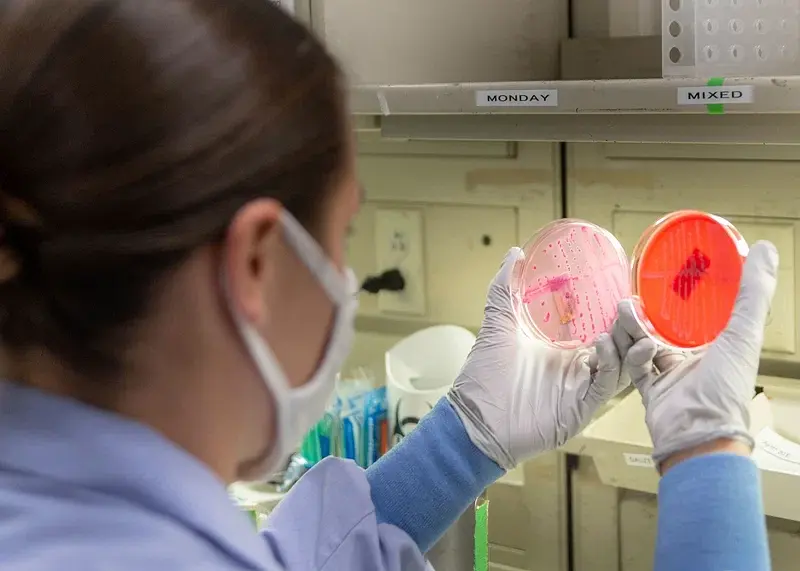
Scientist examining petri dishes with bacterial cultures.

Key Takeaways
- Canada offers a wide range of specialties categorized into clinical, surgical, and laboratory disciplines.
- Each specialty plays a critical role in comprehensive healthcare delivery.
- Understanding specialty paths helps guide medical career choices and patient navigation.
Canada’s healthcare system depends on many medical specialties, each playing an important role in patient care. For aspiring doctors, learning about Canadian medical specialties can guide career choices, while patients can use this knowledge to better navigate their care.
If you plan to become a doctor in Canada, knowing your options is the first step toward choosing the right path.

Categories Of Medical Specialties In Canada
Canada’s healthcare system is supported by a wide range of medical specialties in Canada, each playing a key role in delivering quality care. These categories, like clinical, surgical, and laboratory - ensure patients receive targeted expertise when it’s needed most.
Clinical Specialties
Clinical specialties focus on direct patient care, treating people of all ages and health conditions. As one of the largest groups of Canadian medical specialties, they play a crucial role in maintaining and improving public health.

Family Medicine
Family medicine is the cornerstone of primary care in Canada, delivering continuous healthcare for people of all ages, from routine check-ups to managing chronic conditions.
They are often the first point of contact for patients and play a key role in coordinating care with other medical specialties in Canada. Family medicine is always in high demand in Canada because people need accessible, community-based care.
Pediatrics
Pediatrics focuses on the healthcare needs of infants, children, and adolescents, addressing everything from routine check-ups to complex medical conditions.
While it's not among the highest paying medical specialties Canada offers, pediatrics is one of the most rewarding jobs in medical field Canada for those passionate about improving children’s health and long-term well-being.


Cardiology
Cardiology specializes in diagnosing and treating heart and vascular diseases, which remain leading causes of death in Canada.
Cardiologists are essential for prevention, emergency treatment, and long-term rehabilitation. As one of the highest paying medical specialties Canada offers, cardiology also ranks highly among competitive jobs in medical field Canada, attracting those with a strong interest in life-saving care and advanced medical technology.
Neurology
Neurology focuses on diagnosing and managing conditions of the brain, spinal cord, and nervous system, from migraines and epilepsy to strokes and degenerative diseases like Parkinson’s.
As demand grows for specialized expertise in complex neurological conditions, this field continues to offer rewarding jobs in medical field Canada, with strong opportunities for research and clinical practice.


Dermatology
Dermatology focuses on diagnosing and treating conditions affecting the skin, hair and nails, from common issues like acne and eczema to serious illnesses such as skin cancer.
As one of the highest paying medical specialties Canada offers, dermatology combines clinical expertise with opportunities in cosmetic and surgical procedures, making it a competitive yet rewarding field.
Surgical Specialties
Surgical specialties focus on treating diseases, injuries, and physical abnormalities through operative procedures. These roles are essential for both life-saving interventions and improving quality of life, making them some of the most respected and in some cases, among the highest paying medical specialties in Canada.
In Canada, surgical training and certification are overseen by the Royal College of Physicians and Surgeons of Canada, which sets national standards and accredits residency programs across more than 80 specialties.
General Surgery
General surgeons handle a wide range of operations, from emergency trauma care to common procedures like removing an appendix or gallbladder.
It’s one of the most flexible jobs in the medical field Canada and often works closely with other Canadian medical specialties to give patients the care they need.


Orthopedic Surgery
Orthopedic surgeons treat bone, joint, and muscle issues - from sports injuries to arthritis. In rural Canada, they’re in high demand, and orthopedics can be a well-paid career, especially with a sub-specialty.
Neurosurgery
Neurosurgeons treat brain, spine, and nerve conditions. They perform operations like removing brain tumors or repairing spinal injuries. It’s one of the most complex specialties in Canada and also among the highest paid.


Plastic Surgery
Plastic surgeons do both reconstructive and cosmetic work. They help restore function and appearance after injury or illness, and also perform procedures that enhance appearance.
Cardiovascular & Thoracic Surgery
These surgeons operate on the heart, lungs, and chest. They perform life-saving work like heart bypasses, valve repairs, and lung transplants.
Because of the advanced skills needed, this is one of the highest paying medical specialties Canada offers.

Laboratory Specialties
Laboratory specialties focus on diagnosing disease through testing and analysis rather than direct patient care. While less visible to the public, these Canadian medical specialties are vital for accurate treatment decisions and public health.

Pathology
Pathologists study tissues, cells, and body fluids to detect disease. Their work helps doctors diagnose conditions, plan treatments, and track patient progress.
Medical Microbiology
Focuses on identifying, preventing, and managing infectious diseases caused by bacteria, viruses, fungi, and parasites. Specialists in this field guide treatment plans and help control outbreaks in hospitals and communities.

Clinical Biochemistry
Uses chemical and molecular analysis of blood, urine, and other fluids to help diagnose, monitor, and manage a wide range of health conditions, from diabetes to hormone disorders.
Medical Genetics
Diagnoses, researches, and advises on inherited disorders through genetic testing and counseling. Medical geneticists play a key role in early detection, family planning, and guiding targeted treatment options.

These specialties may be less visible to patients, but they are vital to the healthcare system. There are also many other subspecialties in Canada, such as hematology, immunology, and forensic pathology, each contributing unique expertise.
Pathways To Specialization In Canada
Training to become a medical specialist in Canada takes time and dedication. Whether you choose a clinical, surgical, or laboratory field, each path follows a straightforward process to make sure doctors are fully prepared to deliver safe, high-quality care.
Medical Education And Residency Training
To enter any specialty, you must first complete medical school in Canada - a process that varies slightly if you’re studying medicine as an international student. After earning your MD, graduates move into residency programs, which last between 2 to 5 years depending on the specialty.
Some physicians choose to pursue fellowships to gain expertise in sub-specialties, especially in competitive or highly technical fields. All residency and fellowship programs are accredited by for example the College of Family Physicians of Canada for family medicine or the Royal College of Physicians and Surgeons of Canada for other specialties.
The journey follows a few clear steps - here’s a quick timeline showing how you progress from medical school to becoming a certified specialist.
3–4 years
Medical School
Complete your MD program at a Canadian medical school, learning the foundations of medicine through classroom study and clinical rotations.
2–5 years
Residency
Hands-on specialty training in hospitals or clinics, with length depending on your chosen field.
1–3 years
Fellowship (optional)
Additional training in a sub-specialty to gain advanced skills or expertise in a niche area.
3–12 months
Certification & Licensing
Pass the MCCQE and obtain certification from the relevant college, then apply for your provincial or territorial license to practice.
Licensing And Certification
After completing residency, doctors must obtain a license to practice. This requires passing the Medical Council of Canada Qualifying Examination (MCCQE), which evaluates both clinical knowledge and decision-making. Strong MCCQE exam preparation is critical for success.
Once the exam is passed, certification is granted by the College of Family Physicians of Canada (for family medicine) or the Royal College of Physicians and Surgeons of Canada (for other specialties). Certification confirms physicians are fully qualified, though each province also has its own licensing authority that must approve practice locally.
Demand And Opportunities In Medical Specialties
Healthcare needs in Canada are constantly changing, creating strong demand in some fields while new ones are rapidly emerging. Understanding medical specializations in Canada helps future doctors choose a path that balances personal interests with career opportunities.
🔝 High-Demand Specialties
Some medical fields in Canada face especially high demand because they provide essential, everyday care or support critical health services. These specialties are often at the core of the healthcare system, addressing widespread needs that affect patients across all communities.
The backbone of the system and often the answer to which medical field is most in demand. Family doctors provide ongoing care for people of all ages and are needed across every community.
With growing awareness of mental health, psychiatrists are increasingly essential in both hospitals and private practice.
Critical for safe surgeries and pain management, anesthesiologists remain in steady demand nationwide.
Internists, especially those in cardiology, endocrinology, and geriatrics, play a vital role in diagnosing and managing chronic conditions like diabetes, dementia, and heart disease. With Canada’s aging population, demand for these jobs in medical field Canada continues to rise.
Emergency physicians are in high demand due to overcrowded ERs and staffing shortages. Specialists are sought after across urban hospitals, rural communities, and remote areas, where quick and critical care is essential.
Pediatricians support the unique healthcare needs of children and adolescents. Shortages are common outside large cities, and subspecialties like pediatric oncology and neurology are even more limited.
These high-demand specialties not only offer career security but also make a direct impact on Canada’s healthcare system. For medical graduates considering their options, focusing on these areas ensures both meaningful work and strong employment opportunities within Canadian medical specialties.
📈 Emerging Specialties
As healthcare evolves, new areas of focus are becoming increasingly important. These emerging medical specializations in Canada reflect demographic shifts, scientific advances, and changing patient needs.
With Canada’s aging population, geriatric specialists are vital for managing complex health needs in older adults, from chronic disease to mobility and memory issues.
Focused on improving quality of life for patients with serious or terminal illnesses. This specialty provides pain relief, emotional support, and guidance for families during end-of-life care.
Advances in genetics and genomics are creating new opportunities for early diagnosis and personalized treatments. Specialists in this field help identify inherited conditions and guide preventive care.
These specialties may be smaller today, but they represent the future of Canadian medical specialties. For doctors entering the field, they offer exciting opportunities to shape healthcare in the years ahead.
Choosing The Right Specialty
Deciding on a medical specialty is one of the biggest choices in a doctor’s career. Beyond personal passion, it’s important to weigh lifestyle, training length, and even medical school expenses in Canada when making your decision.
Factors To Consider
Choosing between Canadian medical specialties isn’t just about grades or opportunity, it’s also about what kind of doctor you want to be. The right fit depends on your interests, the lifestyle you’re aiming for, and the job market outlook.
⭐ Personal Interests
Choose a field that fits your strengths and passion - whether it’s patient care, surgery, or research.
🕑 Lifestyle Considerations
Some specialties offer predictable schedules (like dermatology), while others (like surgery or emergency medicine) demand long, irregular hours.
📈 Job Market Trends
Family medicine, psychiatry, and geriatrics are consistently in demand, while other specialties may face higher competition. Researching which medical field is most in demand helps with long-term planning.
Another important factor for many medical students is salary. While passion and lifestyle matter most, understanding the earning potential of different specialties can help with long-term planning. Below is a comparison of medical specialties by salary in Canada.
| Specialty | Average Annual Income (CAD) |
|---|---|
| Ophthalmology | $887,684 |
| Thoracic / Cardiovascular Surgery | $676,495 |
| Neurosurgery | $596,442 |
| Surgical Specialists (overall) | $589,042 |
| Urology | $587,534 |
| General Surgery | $556,349 |
| Cardiology | $547,587 |
| Otolaryngology (ENT) | $539,136 |
| Plastic Surgery | $517,644 |
| Orthopedic Surgery | $522,805 |
| Gastroenterology | $509,951 |
| Obstetrics / Gynecology | $492,006 |
| Dermatology | $491,198 |
| Internal Medicine | $478,287 |
| Medical Specialists (overall) | $421,010 |
| Pediatrics | $375,676 |
| Neurology | $362,936 |
| Physical Medicine | $358,844 |
| Family Medicine | $354,115 |
| Psychiatry | $333,029 |
Salaries vary by province, experience, and work setting, but this table highlights the overall earning potential across specialties. When weighing which medical field is most in demand, remember that financial rewards often align with years of training, complexity of practice, and healthcare system needs.
Resources For Decision-Making
Choosing a medical specialty is easier when you have the right support. Mentorship programs connect students with experienced doctors who can share what daily practice really looks like. Career counseling services at medical schools also help align personal strengths with career prospects, while professional associations provide networking opportunities and specialty-specific guidance. Together, these resources make it easier to navigate the many Canadian medical specialties and move forward with confidence.
Summarize with AI:















